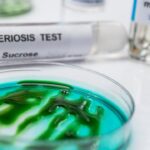
Gene-up Typer : la solution de typage rapide pour identifier l’origine des contaminations à Listeria monocytogenes
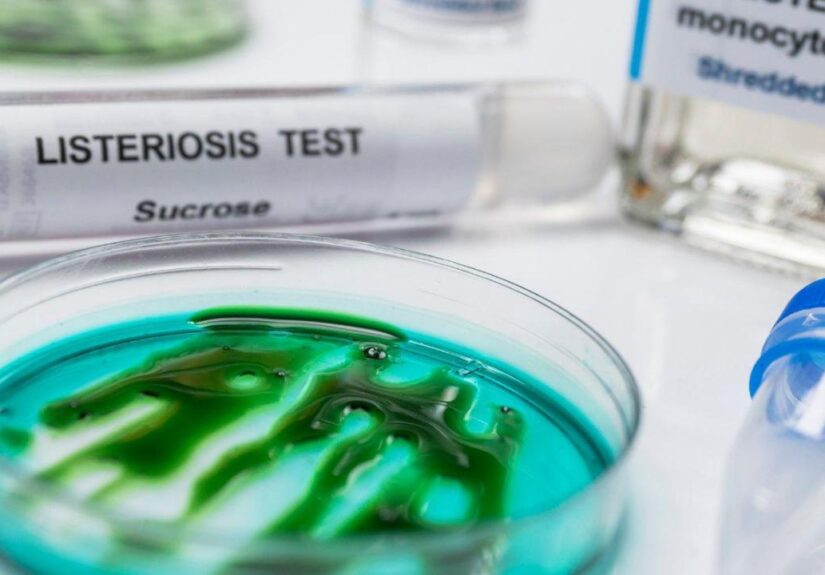
Gene-up Typer : la solution de typage rapide pour identifier l’origine des contaminations à Listeria monocytogenes

{ « @context »: « https://schema.org », « @type »: « Article », « headline »: « Comparatif des Meilleures Téléassistances : Arkéa Assistance, Allovie et Bluelinea en...
Le lait de coco s'est imposé comme un ingrédient incontournable dans nos cuisines modernes, à la fois...
La ville de Cenon, située en Gironde et comptant 24 547 habitants répartis sur une surface de...
Le groupe sanguin représente une caractéristique biologique essentielle qui nous accompagne toute notre vie. Transmis de génération...
Quand une contamination alimentaire par Listeria monocytogenes survient, la question n’est pas seulement de détecter la bactérie...
Durant la grossesse, les futures mamans sont amenées à réaliser plusieurs examens médicaux pour s'assurer du bon...
La chirurgie maxillo-faciale représente une spécialité médicale complexe qui nécessite une expertise pointue et des équipements de...
Le choix d’un lit représente bien plus qu’un simple achat de mobilier. Il s’agit d’une décision qui...
Choisir une résidence autonomie à Besançon représente une décision importante pour les seniors actifs qui souhaitent préserver...
Lorsqu’il s’agit de rendre un dernier hommage à nos proches disparus, le choix des ornements qui décoreront...